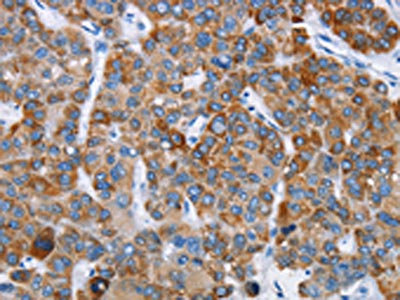

-
中文名稱:CHDH兔多克隆抗體
-
貨號:CSB-PA017354
-
規格:¥1100
-
圖片:
-
The image on the left is immunohistochemistry of paraffin-embedded Human liver cancer tissue using CSB-PA017354(CHDH Antibody) at dilution 1/20, on the right is treated with fusion protein. (Original magnification: ×200)
-
Gel: 10%SDS-PAGE, Lysate: 40 μg, Lane 1-2: 231 cells, mouse kidney tissue, Primary antibody: CSB-PA017354(CHDH Antibody) at dilution 1/400, Secondary antibody: Goat anti rabbit IgG at 1/8000 dilution, Exposure time: 20 seconds
-
-
其他:
產品詳情
-
Uniprot No.:
-
基因名:CHDH
-
別名:CDH antibody; CHD antibody; CHDH antibody; CHDH_HUMAN antibody; Choline dehydrogenase antibody; mitochondrial antibody
-
宿主:Rabbit
-
反應種屬:Human,Mouse,Rat
-
免疫原:Fusion protein of Human CHDH
-
免疫原種屬:Homo sapiens (Human)
-
標記方式:Non-conjugated
-
抗體亞型:IgG
-
純化方式:Antigen affinity purification
-
濃度:It differs from different batches. Please contact us to confirm it.
-
保存緩沖液:-20°C, pH7.4 PBS, 0.05% NaN3, 40% Glycerol
-
產品提供形式:Liquid
-
應用范圍:ELISA,WB,IHC
-
推薦稀釋比:
Application Recommended Dilution ELISA 1:2000-1:5000 WB 1:500-1:2000 IHC 1:25-1:100 -
Protocols:
-
儲存條件:Upon receipt, store at -20°C or -80°C. Avoid repeated freeze.
-
貨期:Basically, we can dispatch the products out in 1-3 working days after receiving your orders. Delivery time maybe differs from different purchasing way or location, please kindly consult your local distributors for specific delivery time.
-
用途:For Research Use Only. Not for use in diagnostic or therapeutic procedures.
相關產品
靶點詳情
-
基因功能參考文獻:
- There is no correlation between single CHDH rs893363 and CHDH rs2289205 polymorphisms and the incidence of intrauterine fetal death. PMID: 28509322
- CHDH gene is located at chromosome 3p21.1, a risk region implicated in previous brains of bipolar disorder genome-wide association studies PMID: 27562178
- In genotypic combination analysis considering PEMT -744GG/CHDH +432GG/BHMT +742GG as the reference combination, PEMT -744GC/CHDH +432GG/BHMT +742GG genotypic combination was significantly higher in mothers of a down syndrome child compared with that in control mothers with an odds ratio of 2.061 (95% CI: 1.10-3.86, P=0.0342). PMID: 27677362
- CHDH is not a substrate of PARK2 but interacts with SQSTM1 independently of PARK2 to recruit SQSTM1 into depolarized mitochondria PMID: 25483962
- the PEMT -774G>C and CHDH +432G>T polymorphisms were associated with sperm concentration. This finding suggests a possible influence of these genes on sperm quality PMID: 22387881
- The rs12676 single nucleotide polymorphism is associated with altered sperm motility patterns and dysmorphic mitochondrial structure in sperm. PMID: 22558321
- CHDH and PLD2 as novel candidate genes, the nucleotide variants of which could be associated with the risk of tooth agenesis. PMID: 21308979
- CHDH A119C and MTHFR C677T play an important role in modulating the homocysteine levels in Indian population. PMID: 20031640
- HOXB13, IL17BR, and CHDH are regulated by estrogen in breast cancer PMID: 17975144
- single nucleotide polymorphisms of choline-metabolizing genes, PEMT -774G>C (rs12325817) and CHDH +432G>T (rs12676), were found be related to breast cancer risk PMID: 18230680
顯示更多
收起更多
-
亞細胞定位:Mitochondrion inner membrane.
-
蛋白家族:GMC oxidoreductase family
-
數據庫鏈接:
Most popular with customers
-
-
YWHAB Recombinant Monoclonal Antibody
Applications: ELISA, WB, IHC, IF, FC
Species Reactivity: Human, Mouse, Rat
-
Phospho-YAP1 (S127) Recombinant Monoclonal Antibody
Applications: ELISA, WB, IHC
Species Reactivity: Human
-
-
-
-
-